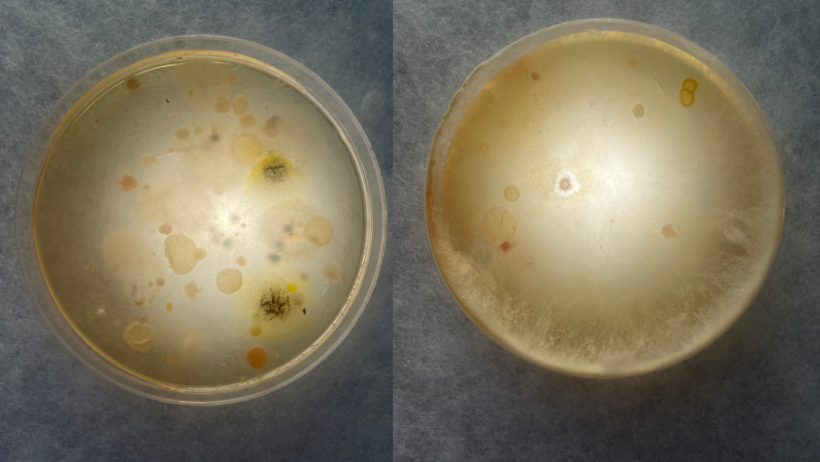
gallery

Ferskur Sàrl
Ferskur Sàrl - Your Expert in Clean Air, Healthy Water, and Efficient Heating.
About Ferskur
Welcome to Ferskur Sàrl, your trusted specialist for a healthy indoor climate, clean air, and pure water in your home.
Our core business includes the maintenance, cleaning, and disinfection of ventilation systems, as well as the cleaning and disinfection of radiators to ensure you breathe clean air at all times.
Additionally, we offer Aquabion's descaling systems and Aquion's water treatment systems to ensure the cleanliness and health of the water in your household. Take advantage of our hydraulic balancing services for efficient heating and cost savings! Trust Ferskur Sàrl.
Our Services :
-Ventilation check
-Ventilation maintenance
-Ventilation cleaning, air conditioner cleaning & disinfection
-Hydraulic balancing of your heating system
-Radiator cleaning and disinfection
-Water treatment
Trust Ferskur Sàrl to make your home healthy and comfortable. Contact us today!
Opening hours of Ferskur
Gallery of Ferskur
Contact persons at Ferskur
Mr. Merlin Olk
Technical manager
Mr. Tom Olk
Administrative manager
General information about Ferskur
Credit card
Additional information about Ferskur
Administrative & financial information
N° Nace
Nettoyage courant des bâtiments (81210)
Trade Register No
B276759
International VAT number
LU34855935
Number of employees
2
Date of foundation
03.2023
-5.png)